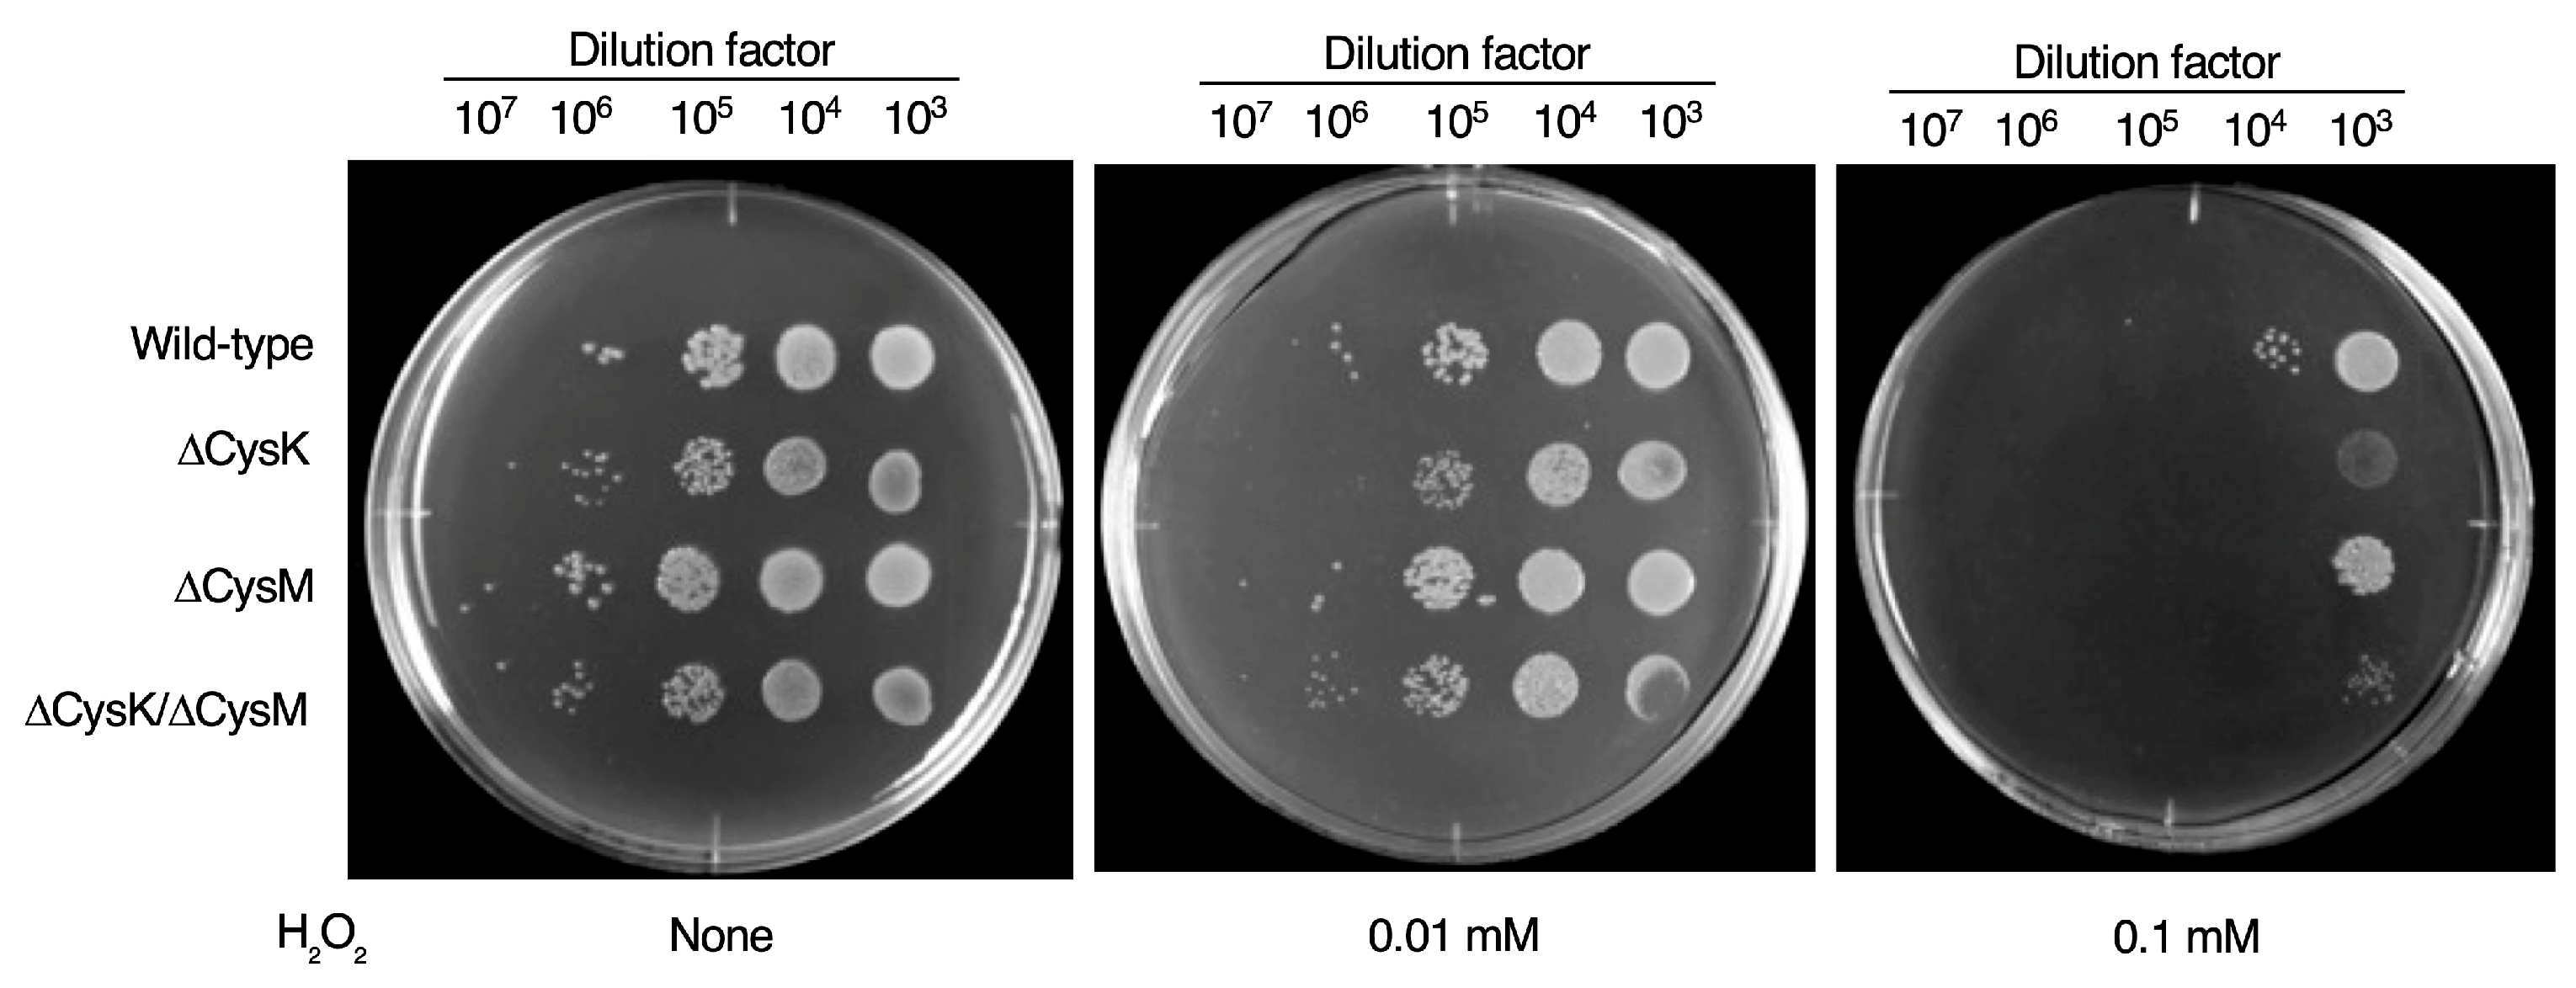
Ijms 26 01106 g006 Ijms 26 01106 g006

Identification of Fungal Metabolite Gliotoxin as a Potent Inhibitor Against Bacterial O-Acetylserine Sulfhydrylase CysK and CysM
Abstract
1. Introduction
2. Results
2.1. Development of an OASS Inhibitor Screening System
2.2. High-Throughput Screening of OASS Inhibitors
2.3. Development of a Bioassay for OASS Inhibitors
2.4. Induction of Oxidative Stress Sensitivity by CysK Deletion
2.5. Bioassay of CysK Inhibitors
2.6. Antibacterial Activity of Gliotoxin
3. Discussion
3.1. Exploration of Bacterial Cysteine Biosynthesis Pathway as an Antimicrobial Target
3.2. OASS Inhibitor Screening
3.3. Discovery of Gliotoxin as a Potent OASS Inhibitor
3.4. Cysteine Uptake Systems as Potential Targets
4. Materials and Methods
4.1. Materials
4.2. Bacterial Strains and Culture Conditions
4.3. Recombinant Enzymes
4.4. High-Throughput Screening System for CysK Inhibitors
4.5. Bioassay for CysK/CysM Inhibitors
4.6. Growth Assay of E. coli CysK, CysM, and CysK/CysM Mutants
4.7. Quantification of Cysteine by LC-MS/MS
4.8. Antibacterial Assay
5. Conclusions
Supplementary Materials
Author Contributions
Funding
Institutional Review Board Statement
Informed Consent Statement
Data Availability Statement
Acknowledgments
Conflicts of Interest
References
- Murray, C.J.L.; Ikuta, K.S.; Sharara, F.; Swetschinski, L.; Aguilar, G.R.; Gray, A.; Han, C.; Bisignano, C.; Rao, P.; Wool, E.; et al. Global Burden of Bacterial Antimicrobial Resistance in 2019: A Systematic Analysis. Lancet 2022, 399, 629–655. [Google Scholar] [CrossRef] [PubMed]
- Jean, S.-S.; Harnod, D.; Hsueh, P.-R. Global Threat of Carbapenem-Resistant Gram-Negative Bacteria. Front. Cell. Infect. Microbiol. 2022, 12, 823684. [Google Scholar] [CrossRef]
- Ma, J.; Song, X.; Li, M.; Yu, Z.; Cheng, W.; Yu, Z.; Zhang, W.; Zhang, Y.; Shen, A.; Sun, H.; et al. Global Spread of Carbapenem-Resistant Enterobacteriaceae: Epidemiological Features, Resistance Mechanisms, Detection and Therapy. Microbiol. Res. 2023, 266, 127249. [Google Scholar] [CrossRef] [PubMed]
- Kohanski, M.A.; Dwyer, D.J.; Hayete, B.; Lawrence, C.A.; Collins, J.J. A Common Mechanism of Cellular Death Induced by Bactericidal Antibiotics. Cell 2007, 130, 797–810. [Google Scholar] [CrossRef] [PubMed]
- Dwyer, D.J.; Belenky, P.A.; Yang, J.H.; MacDonald, I.C.; Martell, J.D.; Takahashi, N.; Chan, C.T.Y.; Lobritz, M.A.; Braff, D.; Schwarz, E.G.; et al. Antibiotics Induce Redox-Related Physiological Alterations as Part of Their Lethality. Proc. Natl. Acad. Sci. USA 2014, 111, E2100–E2109. [Google Scholar] [CrossRef] [PubMed]
- Xiao, G.; Li, J.; Sun, Z. The Combination of Antibiotic and Non-Antibiotic Compounds Improves Antibiotic Efficacy against Multidrug-Resistant Bacteria. Int. J. Mol. Sci. 2023, 24, 15493. [Google Scholar] [CrossRef] [PubMed]
- Alfei, S.; Schito, G.C.; Schito, A.M.; Zuccari, G. Reactive Oxygen Species (ROS)-Mediated Antibacterial Oxidative Therapies: Available Methods to Generate ROS and a Novel Option Proposal. Int. J. Mol. Sci. 2024, 25, 7182. [Google Scholar] [CrossRef]
- Leustek, T.; Martin, M.N.; Bick, J.-A.; Davies, J.P. Pathways and regulation of sulfur metabolism revealed through molecular and genetic studies. Annu. Rev. Plant Biol. 2000, 51, 141–165. [Google Scholar] [CrossRef]
- Kessler, D. Enzymatic Activation of Sulfur for Incorporation into Biomolecules in Prokaryotes. FEMS Microbiol. Rev. 2006, 30, 825–840. [Google Scholar] [CrossRef]
- Verma, D.; Gupta, V. New Insights into the Structure and Function of an Emerging Drug Target CysE. 3 Biotech 2021, 11, 373. [Google Scholar] [CrossRef]
- Tai, C.H.; Nalabolu, S.R.; Jacobson, T.M.; Minter, D.E.; Cook, P.F. Kinetic Mechanisms of the A and B Isozymes of O-Acetylserine Sulfhydrylase from Salmonella Typhimurium LT-2 Using the Natural and Alternate Reactants. Biochemistry 1993, 32, 6433–6442. [Google Scholar] [CrossRef] [PubMed]
- Toyomoto, T.; Ono, K.; Shiba, T.; Momitani, K.; Zhang, T.; Tsutsuki, H.; Ishikawa, T.; Hoso, K.; Hamada, K.; Rahman, A.; et al. Alkyl Gallates Inhibit Serine O-Acetyltransferase in Bacteria and Enhance Susceptibility of Drug-Resistant Gram-Negative Bacteria to Antibiotics. Front. Microbiol. 2023, 14, 1276447. [Google Scholar] [CrossRef] [PubMed]
- Verma, D.; Gupta, S.; Saxena, R.; Kaur, P.; Rachana, R.; Srivastava, S.; Gupta, V. Allosteric Inhibition and Kinetic Characterization of Klebsiella Pneumoniae CysE: An Emerging Drug Target. Int. J. Biol. Macromol. 2020, 151, 1240–1249. [Google Scholar] [CrossRef]
- Qin, Y.; Teng, Y.; Yang, Y.; Mao, Z.; Zhao, S.; Zhang, N.; Li, X.; Niu, W. Advancements in Inhibitors of Crucial Enzymes in the Cysteine Biosynthetic Pathway: Serine Acetyltransferase and O-Acetylserine Sulfhydrylase. Chem. Biol. Drug Des. 2024, 104, e14573. [Google Scholar] [CrossRef]
- Ida, T.; Sawa, T.; Ihara, H.; Tsuchiya, Y.; Watanabe, Y.; Kumagai, Y.; Suematsu, M.; Motohashi, H.; Fujii, S.; Matsunaga, T.; et al. Reactive Cysteine Persulfides and S-Polythiolation Regulate Oxidative Stress and Redox Signaling. Proc. Natl. Acad. Sci. USA 2014, 111, 7606–7611. [Google Scholar] [CrossRef]
- Sawa, T.; Motohashi, H.; Ihara, H.; Akaike, T. Enzymatic Regulation and Biological Functions of Reactive Cysteine Persulfides and Polysulfides. Biomolecules 2020, 10, 1245. [Google Scholar] [CrossRef]
- Barayeu, U.; Sawa, T.; Nishida, M.; Wei, F.-Y.; Motohashi, H.; Akaike, T. Supersulfide Biology and Translational Medicine for Disease Control. Br. J. Pharmacol. 2023. [Google Scholar] [CrossRef]
- Akaike, T.; Morita, M.; Ogata, S.; Yoshitake, J.; Jung, M.; Sekine, H.; Motohashi, H.; Barayeu, U.; Matsunaga, T. New Aspects of Redox Signaling Mediated by Supersulfides in Health and Disease. Free Radic. Biol. Med. 2024, 222, 539–551. [Google Scholar] [CrossRef]
- Ono, K.; Kitamura, Y.; Zhang, T.; Tsutsuki, H.; Rahman, A.; Ihara, T.; Akaike, T.; Sawa, T. Cysteine Hydropersulfide Inactivates β-Lactam Antibiotics with Formation of Ring-Opened Carbothioic S-Acids in Bacteria. ACS Chem. Biol. 2021, 16, 731–739. [Google Scholar] [CrossRef]
- Richard, J.L.; Debey, M.C.; Chermette, R.; Pier, A.C.; Hasegawa, A.; Lund, A.; Bratberg, A.M.; Padhye, A.A.; Connole, M.D. Advances in Veterinary Mycology. J. Med. Vet. Mycol. 1994, 32, 169–187. [Google Scholar] [CrossRef]
- Sutton, P.; Newcombe, N.R.; Waring, P.; Müllbacher, A. In Vivo Immunosuppressive Activity of Gliotoxin, a Metabolite Produced by Human Pathogenic Fungi. Infect. Immun. 1994, 62, 1192–1198. [Google Scholar] [CrossRef] [PubMed]
- Waring, P.; Beaver, J. Gliotoxin and Related Epipolythiodioxopiperazines. Gen. Pharmacol. Vasc. Syst. 1996, 27, 1311–1316. [Google Scholar] [CrossRef] [PubMed]
- Gardiner, D.M.; Waring, P.; Howlett, B.J. The Epipolythiodioxopiperazine (ETP) Class of Fungal Toxins: Distribution, Mode of Action, Functions and Biosynthesis. Microbiology 2005, 151, 1021–1032. [Google Scholar] [CrossRef] [PubMed]
- Sasakura, K.; Hanaoka, K.; Shibuya, N.; Mikami, Y.; Kimura, Y.; Komatsu, T.; Ueno, T.; Terai, T.; Kimura, H.; Nagano, T. Development of a Highly Selective Fluorescence Probe for Hydrogen Sulfide. J. Am. Chem. Soc. 2011, 133, 18003–18005. [Google Scholar] [CrossRef]
- Hanaoka, K.; Sasakura, K.; Suwanai, Y.; Toma-Fukai, S.; Shimamoto, K.; Takano, Y.; Shibuya, N.; Terai, T.; Komatsu, T.; Ueno, T.; et al. Discovery and Mechanistic Characterization of Selective Inhibitors of H2S-Producing Enzyme: 3-Mercaptopyruvate Sulfurtransferase (3MST) Targeting Active-Site Cysteine Persulfide. Sci. Rep. 2017, 7, 40227. [Google Scholar] [CrossRef]
- Kredich, N.M.; Foote, L.J.; Hulanicka, M.D. Studies on the Mechanism of Inhibition of Salmonella Typhimurium by 1,2,4-Triazole. J. Biol. Chem. 1975, 250, 7324–7331. [Google Scholar] [CrossRef]
- Scharf, D.H.; Brakhage, A.A.; Mukherjee, P.K. Gliotoxin--Bane or Boon? Environ. Microbiol. 2016, 18, 1096–1109. [Google Scholar] [CrossRef]
- Smirnova, G.; Tyulenev, A.; Sutormina, L.; Kalashnikova, T.; Muzyka, N.; Ushakov, V.; Samoilova, Z.; Oktyabrsky, O. Regulation of Cysteine Homeostasis and Its Effect on Escherichia coli Sensitivity to Ciprofloxacin in LB Medium. Int. J. Mol. Sci. 2024, 25, 4424. [Google Scholar] [CrossRef]
- Douafer, H.; Andrieu, V.; Phanstiel, O.; Brunel, J.M. Antibiotic Adjuvants: Make Antibiotics Great Again! J. Med. Chem. 2019, 62, 8665–8681. [Google Scholar] [CrossRef]
- Li, W.; Tao, Z.; Zhou, M.; Jiang, H.; Wang, L.; Ji, B.; Zhao, Y. Antibiotic Adjuvants against Multidrug-Resistant Gram-Negative Bacteria: Important Component of Future Antimicrobial Therapy. Microbiol. Res. 2024, 287, 127842. [Google Scholar] [CrossRef]
- Kumar, V.; Yasmeen, N.; Pandey, A.; Ahmad Chaudhary, A.; Alawam, A.S.; Ahmad Rudayni, H.; Islam, A.; Lakhawat, S.S.; Sharma, P.K.; Shahid, M. Antibiotic Adjuvants: Synergistic Tool to Combat Multi-Drug Resistant Pathogens. Front. Cell. Infect. Microbiol. 2023, 13, 1293633. [Google Scholar] [CrossRef] [PubMed]
- Claus, M.T.; Zocher, G.E.; Maier, T.H.P.; Schulz, G.E. Structure of the O-Acetylserine Sulfhydrylase Isoenzyme CysM from Escherichia coli. Biochemistry 2005, 44, 8620–8626. [Google Scholar] [CrossRef] [PubMed]
- Spyrakis, F.; Singh, R.; Cozzini, P.; Campanini, B.; Salsi, E.; Felici, P.; Raboni, S.; Benedetti, P.; Cruciani, G.; Kellogg, G.E.; et al. Isozyme-Specific Ligands for O-Acetylserine Sulfhydrylase, a Novel Antibiotic Target. PLoS ONE 2013, 8, e77558. [Google Scholar] [CrossRef]
- Tai, C.-H.; Cook, P.F. Pyridoxal 5’-Phosphate-Dependent α,β-Elimination Reactions: Mechanism of O-Acetylserine Sulfhydrylase. Acc. Chem. Res. 2001, 34, 49–59. [Google Scholar] [CrossRef]
- Zhou, Y.; Yu, F.; Chen, M.; Zhang, Y.; Qu, Q.; Wei, Y.; Xie, C.; Wu, T.; Liu, Y.; Zhang, Z.; et al. Tylosin Inhibits Streptococcus Suis Biofilm Formation by Interacting with the O-Acetylserine (Thiol)-Lyase B CysM. Front. Vet. Sci. 2021, 8, 829899. [Google Scholar] [CrossRef]
- Brunner, K.; Maric, S.; Reshma, R.S.; Almqvist, H.; Seashore-Ludlow, B.; Gustavsson, A.-L.; Poyraz, Ö.; Yogeeswari, P.; Lundbäck, T.; Vallin, M.; et al. Inhibitors of the Cysteine Synthase CysM with Antibacterial Potency against Dormant Mycobacterium tuberculosis. J. Med. Chem. 2016, 59, 6848–6859. [Google Scholar] [CrossRef]
- Hurne, A.M.; Chai, C.L.L.; Waring, P. Inactivation of Rabbit Muscle Creatine Kinase by Reversible Formation of an Internal Disulfide Bond Induced by the Fungal Toxin Gliotoxin. J. Biol. Chem. 2000, 275, 25202–25206. [Google Scholar] [CrossRef]
- Waring, P.; Sjaarda, A.; Lin, Q.H. Gliotoxin Inactivates Alcohol Dehydrogenase by Either Covalent Modification or Free Radical Damage Mediated by Redox Cycling. Biochem. Pharmacol. 1995, 49, 1195–1201. [Google Scholar] [CrossRef]
- Bernardo, P.H.; Chai, C.L.L.; Deeble, G.J.; Liu, X.-M.; Waring, P. Evidence for Gliotoxin–Glutathione Conjugate Adducts. Bioorg. Med. Chem. Lett. 2001, 11, 483–485. [Google Scholar] [CrossRef]
- Salsi, E.; Bayden, A.S.; Spyrakis, F.; Amadasi, A.; Campanini, B.; Bettati, S.; Dodatko, T.; Cozzini, P.; Kellogg, G.E.; Cook, P.F.; et al. Design of O-Acetylserine Sulfhydrylase Inhibitors by Mimicking Nature. J. Med. Chem. 2010, 53, 345–356. [Google Scholar] [CrossRef]
- Pieroni, M.; Annunziato, G.; Beato, C.; Wouters, R.; Benoni, R.; Campanini, B.; Pertinhez, T.A.; Bettati, S.; Mozzarelli, A.; Costantino, G. Rational Design, Synthesis, and Preliminary Structure-Activity Relationships of α-Substituted-2-Phenylcyclopropane Carboxylic Acids as Inhibitors of Salmonella Typhimurium O-Acetylserine Sulfhydrylase. J. Med. Chem. 2016, 59, 2567–2578. [Google Scholar] [CrossRef] [PubMed]
- Annunziato, G.; Pieroni, M.; Benoni, R.; Campanini, B.; Pertinhez, T.A.; Pecchini, C.; Bruno, A.; Magalhães, J.; Bettati, S.; Franko, N.; et al. Cyclopropane-1,2-Dicarboxylic Acids as New Tools for the Biophysical Investigation of O-Acetylserine Sulfhydrylases by Fluorimetric Methods and Saturation Transfer Difference (STD) NMR. J. Enzym. Inhib. Med. Chem. 2016, 31, 78–87. [Google Scholar] [CrossRef] [PubMed]
- Magalhães, J.; Franko, N.; Annunziato, G.; Welch, M.; Dolan, S.K.; Bruno, A.; Mozzarelli, A.; Armao, S.; Jirgensons, A.; Pieroni, M.; et al. Discovery of Novel Fragments Inhibiting O-Acetylserine Sulphhydrylase by Combining Scaffold Hopping and Ligand-Based Drug Design. J. Enzym. Inhib. Med. Chem. 2018, 33, 1444–1452. [Google Scholar] [CrossRef] [PubMed]
- Marchetti, M.; De Angelis, F.S.; Annunziato, G.; Costantino, G.; Pieroni, M.; Ronda, L.; Mozzarelli, A.; Campanini, B.; Cannistraro, S.; Bizzarri, A.R.; et al. A Competitive O-Acetylserine Sulfhydrylase Inhibitor Modulates the Formation of Cysteine Synthase Complex. Catalysts 2021, 11, 700. [Google Scholar] [CrossRef]
- Annunziato, G.; Spadini, C.; Marchetti, M.; Franko, N.; Pavone, M.; Iannarelli, M.; Bruno, A.; Pieroni, M.; Bettati, S.; Cabassi, C.S.; et al. Inhibitors of O-Acetylserine Sulfhydrylase with a Cyclopropane-Carboxylic Acid Scaffold Are Effective Colistin Adjuvants in Gram Negative Bacteria. Pharmaceuticals 2022, 15, 766. [Google Scholar] [CrossRef]
- Poyraz, Ö.; Jeankumar, V.U.; Saxena, S.; Schnell, R.; Haraldsson, M.; Yogeeswari, P.; Sriram, D.; Schneider, G. Structure-Guided Design of Novel Thiazolidine Inhibitors of O-Acetyl Serine Sulfhydrylase from Mycobacterium tuberculosis. J. Med. Chem. 2013, 56, 6457–6466. [Google Scholar] [CrossRef]
- Brunner, K.; Steiner, E.M.; Reshma, R.S.; Sriram, D.; Schnell, R.; Schneider, G. Profiling of in Vitro Activities of Urea-Based Inhibitors against Cysteine Synthases from Mycobacterium tuberculosis. Bioorg. Med. Chem. Lett. 2017, 27, 4582–4587. [Google Scholar] [CrossRef]
- Franko, N.; Grammatoglou, K.; Campanini, B.; Costantino, G.; Jirgensons, A.; Mozzarelli, A. Inhibition of O-Acetylserine Sulfhydrylase by Fluoroalanine Derivatives. J. Enzym. Inhib. Med. Chem. 2018, 33, 1343–1351. [Google Scholar] [CrossRef]
- Wallace, M.J.; Dharuman, S.; Fernando, D.M.; Reeve, S.M.; Gee, C.T.; Yao, J.; Griffith, E.C.; Phelps, G.A.; Wright, W.C.; Elmore, J.M.; et al. Discovery and Characterization of the Antimetabolite Action of Thioacetamide-Linked 1,2,3-Triazoles as Disruptors of Cysteine Biosynthesis in Gram-Negative Bacteria. ACS Infect. Dis. 2020, 6, 467–478. [Google Scholar] [CrossRef]
- Chonoles Imlay, K.R.; Korshunov, S.; Imlay, J.A. Physiological Roles and Adverse Effects of the Two Cystine Importers of Escherichia coli. J. Bacteriol. 2015, 197, 3629–3644. [Google Scholar] [CrossRef]
- Ohtsu, I.; Kawano, Y.; Suzuki, M.; Morigasaki, S.; Saiki, K.; Yamazaki, S.; Nonaka, G.; Takagi, H. Uptake of L-Cystine via an ABC Transporter Contributes Defense of Oxidative Stress in the L-Cystine Export-Dependent Manner in Escherichia coli. PLoS ONE 2015, 10, e0120619. [Google Scholar] [CrossRef] [PubMed]
- Sabrialabed, S.; Yang, J.G.; Yariv, E.; Ben-Tal, N.; Lewinson, O. Substrate Recognition and ATPase Activity of the E. coli Cysteine/Cystine ABC Transporter YecSC-FliY. J. Biol. Chem. 2020, 295, 5245–5256. [Google Scholar] [CrossRef] [PubMed]
- Ono, K.; Jung, M.; Zhang, T.; Tsutsuki, H.; Sezaki, H.; Ihara, H.; Wei, F.-Y.; Tomizawa, K.; Akaike, T.; Sawa, T. Synthesis of L-Cysteine Derivatives Containing Stable Sulfur Isotopes and Application of This Synthesis to Reactive Sulfur Metabolome. Free Radic. Biol. Med. 2017, 106, 69–79. [Google Scholar] [CrossRef]

Disclaimer/Publisher’s Note: The statements, opinions and data contained in all publications are solely those of the individual author(s) and contributor(s) and not of MDPI and/or the editor(s). MDPI and/or the editor(s) disclaim responsibility for any injury to people or property resulting from any ideas, methods, instructions or products referred to in the content. |
© 2025 by the authors. Licensee MDPI, Basel, Switzerland. This article is an open access article distributed under the terms and conditions of the Creative Commons Attribution (CC BY) license (https://creativecommons.org/licenses/by/4.0/).
Share and Cite
Rahman, A.; Ono, K.; Toyomoto, T.; Hanaoka, K.; Sawa, T. Identification of Fungal Metabolite Gliotoxin as a Potent Inhibitor Against Bacterial O-Acetylserine Sulfhydrylase CysK and CysM. Int. J. Mol. Sci. 2025, 26, 1106. https://doi.org/10.3390/ijms26031106
Rahman A, Ono K, Toyomoto T, Hanaoka K, Sawa T. Identification of Fungal Metabolite Gliotoxin as a Potent Inhibitor Against Bacterial O-Acetylserine Sulfhydrylase CysK and CysM. International Journal of Molecular Sciences. 2025; 26(3):1106. https://doi.org/10.3390/ijms26031106
Chicago/Turabian StyleRahman, Azizur, Katsuhiko Ono, Touya Toyomoto, Kenjiro Hanaoka, and Tomohiro Sawa. 2025. "Identification of Fungal Metabolite Gliotoxin as a Potent Inhibitor Against Bacterial O-Acetylserine Sulfhydrylase CysK and CysM" International Journal of Molecular Sciences 26, no. 3: 1106. https://doi.org/10.3390/ijms26031106
APA StyleRahman, A., Ono, K., Toyomoto, T., Hanaoka, K., & Sawa, T. (2025). Identification of Fungal Metabolite Gliotoxin as a Potent Inhibitor Against Bacterial O-Acetylserine Sulfhydrylase CysK and CysM. International Journal of Molecular Sciences, 26(3), 1106. https://doi.org/10.3390/ijms26031106

